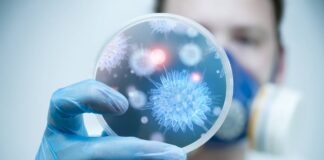
La física cuántica colabora en la lucha contra las infecciones y el cáncer

Etiqueta: Física cuántica
Revelan la naturaleza cuántica de la interacción fotón/electrón libre
Israel., 4 Oct-21 (Agencia).- Investigadores del Technion-Instituto de Tecnología de Israel han recopilado la primera evidencia experimental que revela la naturaleza cuántica de la...
Es hora de entender qué es la física cuántica
España., 16 Ago-21 (Agencia).- La física cuántica lleva décadas dando mucho que hablar. Ha impulsado movimientos culturales, una mayor comprensión sobre la naturaleza del...
¿Puede la Física Cuántica predecir el azar?
FÍSICA CLÁSICA: EL DETERMINISMO NO SIGNIFICA PREVISIBILIDAD
Ciencia & Tecnologia., 3 Jul-21 (Agencia).- El determinismo es la idea de que podemos predecir el comportamiento futuro...
El tiempo existe y no existe en un túnel cuántico
(Agencia / 3 Sept-20).- En nuestro mundo, si golpeamos una pelota con un pie a la entrada de un túnel, podemos calcular cuándo saldrá...
La física cuántica colabora en la lucha contra las infecciones y...
Estados Unidos., 3 Sept-20 (Agencia).- Científicos de la Clínica Cleveland y de la Universidad Case Western Reserve de Estados Unidos han unido los esfuerzos...